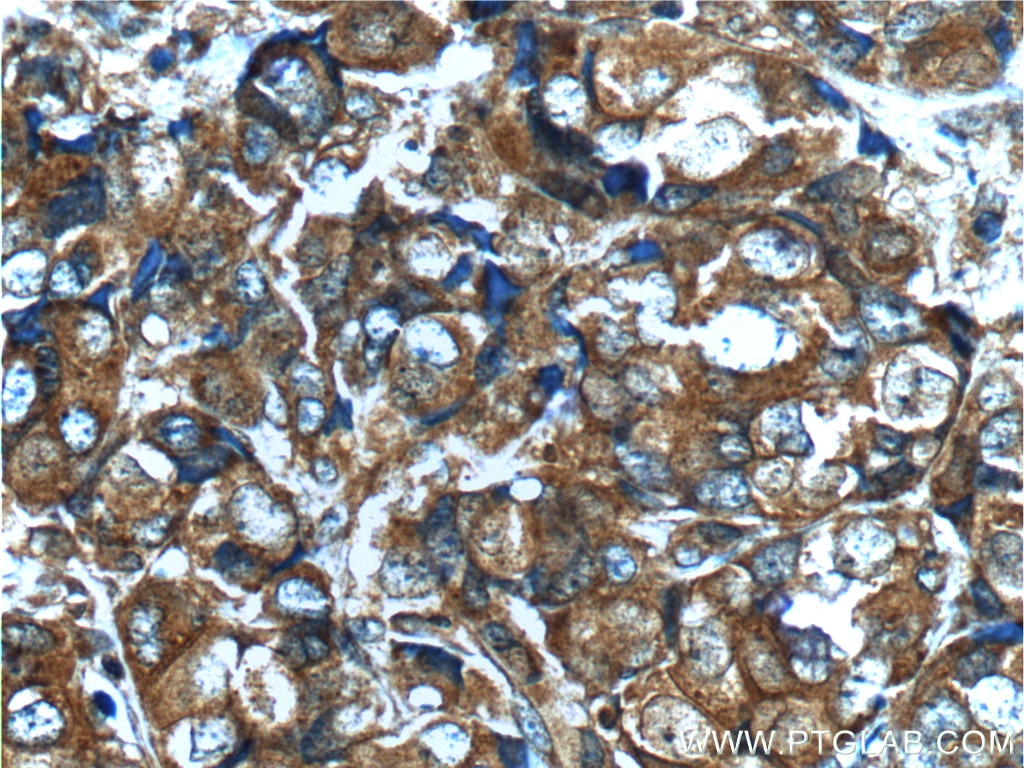

|
※サムネイル画像をクリックすると拡大画像が表示されます。
|
|
|
| 別品名 |
FGFR2, BEK, BFR 1, CD332, CEK3
|
| 別包装 |
あり
|
| 種由来 |
Human
|
| 交差種 |
Human
|
| 適用 |
IHC paraffin embedding section
Enzyme Linked Immunosorbent Assay
Immuno Fluorescence
Immunocytochemistry (cell)
Intracellular Staining for Flow Cytometry
|
| 免疫動物 |
Rabbit
|
| 抗体クラス |
IgG
|
| 標識物 |
Unlabeled
|
| 精製度 |
Affinity Purified
|
| GENE ID |
2263
|
| Accession No.(Gene/Protein) |
BC039243
|
| 概要 |
The FGFR2 antibody from Proteintech is a rabbit polyclonal antibody to a recombinant protein of human FGFR2. This antibody recognizes human antigen. The FGFR2 antibody has been validated for the following applications: IHC, IF/ICC, FC (Intra), ELISA analysis.
|
| その他 |
[Buffer]PBS with 0.02% sodium azide and 50% glycerol pH 7.3.
|
| 使用文献 |
[Pub Med ID] 28469963, 34787070, 33957627, 34487480, 36143417, 36305369, 36494846
|
|
| メーカー |
品番 |
包装 |
|
PGI
|
13042-1-AP
|
150 UL
|
※表示価格について
|
※当社では商品情報の適切な管理に努めておりますが、表示される法規制情報は最新でない可能性があります。
また法規制情報の表示が無いものは、必ずしも法規制に非該当であることを示すものではありません。
商品のお届け前に最新の製品法規制情報をお求めの際はこちらへお問い合わせください。
|
※当社取り扱いの試薬・機器製品および受託サービス・創薬支援サービス(納品物、解析データ等)は、研究用としてのみ販売しております。
人や動物の医療用・臨床診断用・食品用としては、使用しないように、十分ご注意ください。
法規制欄に体外診断用医薬品と記載のものは除きます。
|
|
※リンク先での文献等のダウンロードに際しましては、掲載元の規約遵守をお願いします。
|
|
※CAS Registry Numbers have not been verified by CAS and may be inaccurate.
|